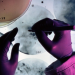
Bild 6

Cold Case Files - Wahre Fälle der US-Ermittler (Cold Case Files)
Cold Case Files - Logo
Bildauswahl:

Cold Case Files - Logo

.

.

.

.
Vor allem die DNA-Analyse gibt den Cops heutzutage die Möglichkeit, Täter endlich zu überführen ...

Original Tatort-Fotos, Video-Ausschnitte aus den Verhören und Interviews mit Angehörigen geben einen spannenden und genauen Eindruck von den spektakulärsten Fällen der jüngeren amerikanischen Kriminalgeschichte ...

In den Archiven amerikanischer Police Departments lagern Zehntausende von Akten, die von Mord und schweren Gewaltverbrechen berichten. Hier finden die so genannten "Cold Case Detectives" immer wieder Fälle, die sich erst jetzt -vielleicht- aufklären lassen ...

.
Übersicht
Themen
Details
Hinweis
1 weiterer Sendetermin
| Sender | Datum | Uhrzeit | ||
|---|---|---|---|---|
| kabel eins Doku | Do 12.2. | 03:35 | Cold Case Files - Wahre Fälle der US-Ermittler Tödliches Inferno | Sendung zum Merkzettel hinzufügen |
- in Kalender eintragen
in Kalender eintragen
-
Sendung eintragen in:
Kalender
Google Kalender
-
-
Sendung hinzufügen
zum Merkzettel hinzufügen
-
+ Sendung als TV-Agent einrichten
als TV-Agent einrichten
-
Freunde per Email informieren
per Email informieren
-
in Website einbetten
- 1 weiterer Sendetermin
weitere Sendetermine

